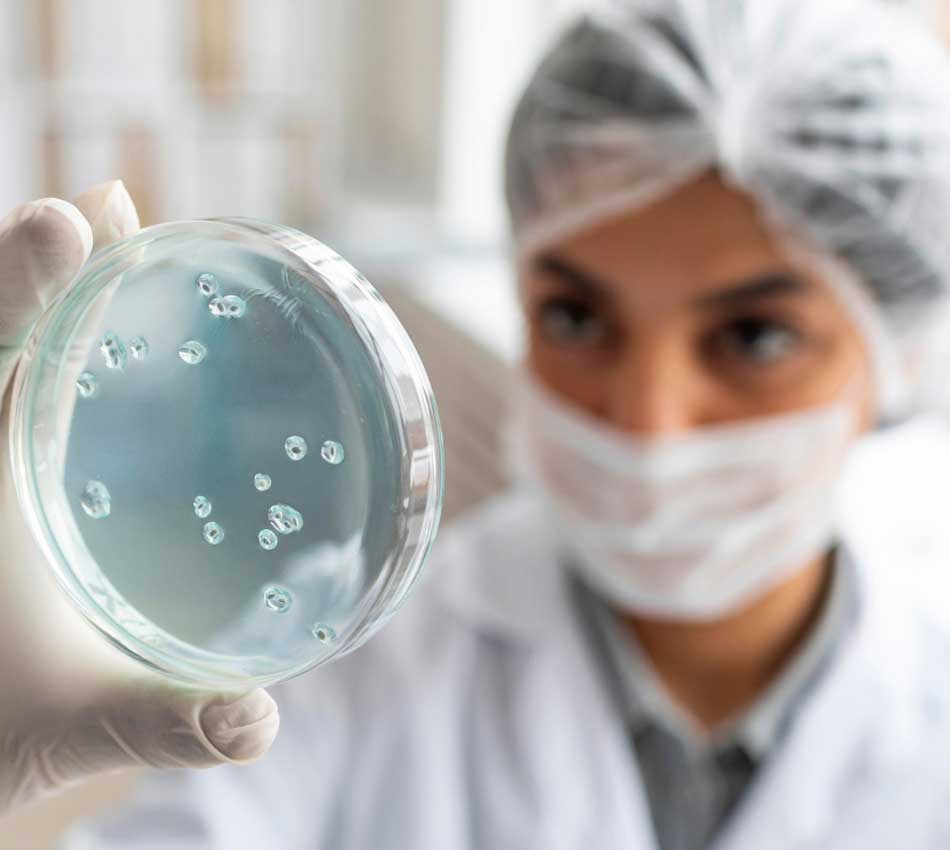

Biotechnology Internship
This Biotechnology Internship serves as a definitive bridge between university coursework and the high-demand world of industrial R&D, providing undergraduate students with the technical mastery and professional confidence needed to excel in a laboratory career. Throughout the program, you will transition from theoretical concepts to practical applications, gaining hands-on exposure to critical techniques such as PCR amplification, CRISPR-mediated gene editing, and mammalian cell culture.
Microbiology Internship
This Microbiology Internship is an intensive, skills-focused program designed to transform undergraduate students into proficient laboratory scientists by mastering the “Five I’s” of microbiology: Inoculation, Incubation, Isolation, Inspection, and Identification. Throughout the course, participants will gain hands-on expertise in aseptic techniques and the cultivation of diverse microbial cultures, ranging from environmental isolates to clinical pathogens.

Food Technology Internship
This Food Technology Internship is an industry-centric program designed to equip undergraduate students with the scientific and engineering expertise required to manage the entire “farm-to-fork” lifecycle. Participants will gain specialized skills in food chemistry, nutrient analysis, and microbial safety, alongside hands-on training in core processing techniques such as thermal preservation, dehydration, and fermentation.

Molecular Biology
This Molecular Biology Internship is an elite, research-driven program designed to immerse undergraduate students in the fundamental mechanisms of life at the molecular level, focusing on the manipulation and analysis of nucleic acids and proteins. Participants will develop advanced technical proficiency in genomic DNA and RNA extraction, primer design, and the optimization of various PCR modalities, including quantitative real-time PCR (qPCR).

Bioinformatics
This Bioinformatics Internship is a specialized, data-driven program designed to bridge the gap between biological inquiry and computational analysis, preparing students for the rapidly evolving field of “dry-lab” research. Participants will develop technical proficiency in managing large-scale biological datasets, mastering the use of Python or R for biological programming and the command-line interface for high-throughput genomic analysis.

Botany
This Botany Internship is a specialized, immersive program designed to transition undergraduate students from basic plant awareness to professional botanical expertise, focusing on the scientific study of plant life from the molecular to the ecosystem level. Participants will master essential field and laboratory techniques, including plant species identification through taxonomic keys, the quadrat method for vegetation analysis, and advanced herbarium specimen preservation.

Zoology and Entomology
This Zoology Internship is an intensive, research-oriented program designed to provide students with a deep understanding of animal biology, physiology, and behavioral ecology through both field and laboratory expertise. Participants will gain hands-on training in animal anatomy and comparative morphology, mastering dissection techniques and the use of histological tools to examine tissue structures.

Phytochemistry
This Phytochemistry Internship is an advanced analytical program designed to train students in the systematic study of bioactive compounds derived from plants, moving from raw botanical matter to isolated pure molecules. By integrating principles of bio-assay guided fractionation and structural elucidation, the program prepares interns for specialized careers in natural product research, pharmacognosy, and the development of plant-based therapeutic agents.

Biochemistry
This Biochemistry Internship is a rigorous, interdisciplinary program designed to bridge the gap between chemical principles and biological systems, providing students with the analytical mastery required for advanced research and diagnostic careers. By integrating training in buffer preparation, pH standardization, and the use of sophisticated instrumentation like HPLC and UV-Vis spectrophotometers.

Enzymology
This Enzymology Internship is a rigorous, biochemically-focused program designed to provide students with deep technical expertise in the isolation, characterization, and industrial application of biological catalysts. Participants will master the fundamental principles of enzyme kinetics, gaining hands-on experience in determining Michaelis-Menten constants ($K_m$ and $V_{max}$) and understanding the mechanisms of enzyme inhibition and activation.

Herbal Drug Formulation
This Herbal Drug Formulation Internship is a specialized, multidisciplinary program designed to train students in the scientific transformation of medicinal plants into standardized pharmaceutical products. Participants will develop expertise in the entire development lifecycle, starting from the botanical authentication of raw materials and advanced extraction techniques.

Nanotechnology
This Nanotechnology Internship is a high-tech, multidisciplinary program designed to introduce students to the unique physical and chemical properties of matter at the nanoscale ($10^{-9}$ meters). Participants will develop specialized expertise in the “top-down” and “bottom-up” synthesis of nanomaterials, gaining hands-on experience in producing metallic nanoparticles, carbon nanotubes, and nanocomposites.
